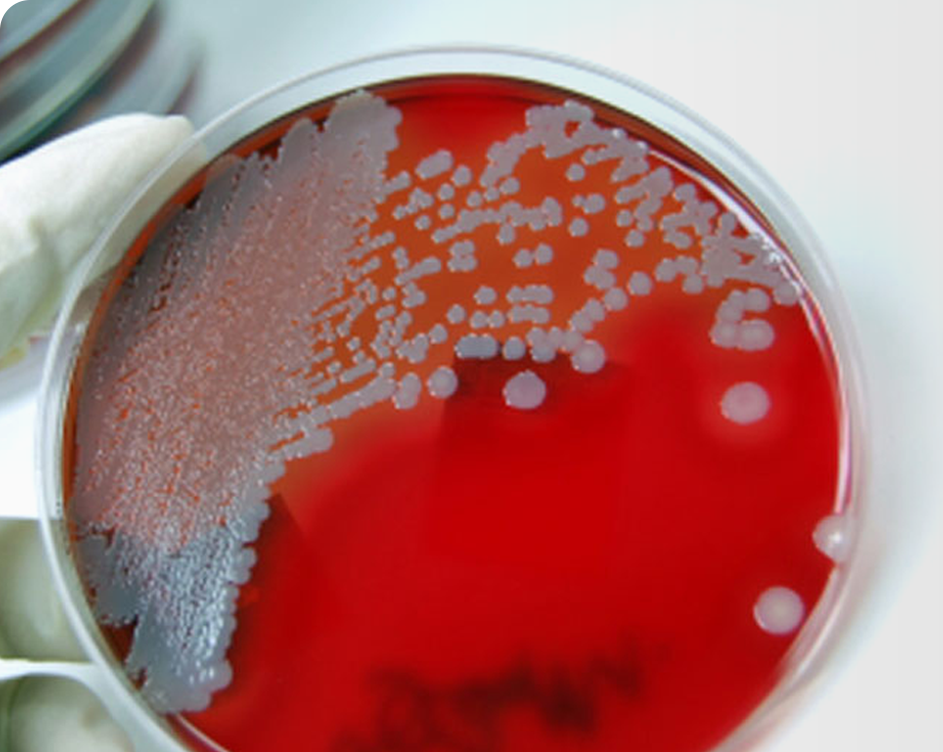

Bacteria are a large domain of microorganisms of varying shapes and sizes. Present in most habitats on Earth including soil and water, the typical bacteria count in a gram of soil is near 40 million bacteria. Bacteria are present in the human body to help digest food among other supportive functions. Bacteria can also be harmful to humans when bacteria from the digestive tracts of animals or humans end up in food or water sources. Furthermore, regardless of the medium in which bacteria reside, they are odorless, tasteless, and invisible to the human eye. Thus, the only reliable method of bacteria identification and quantification for the determination of sanitary conditions is through laboratory testing. Please note that Atlas Environmental reports both potable and non-potable water results in CFU (number of colonies) per milliliter of sample. For more information on total bacteria count in water, please visit the Environmental Protection Agency’s Water Website.
Total Bacteria Count (HPC) for Potable and Non-Potable Water